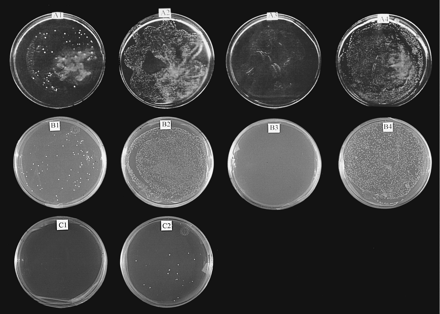
Figure 6.

LAG1Ce-1 and LAG1Hs complement theLAG1Sc/LAC1Sc deletion. (A)LAG1Ce-1 transformants. (A1) Diploid cells on a leu−, trp−, ura+, and 5-FOA+ plate. (A2) Same cells as A1, but on a leu−, trp−, and ura− plate. (A3) Haploid cells on a leu−, trp−, ura+ and 5-FOA+ plate. (A4) Same cells as A3, but on a leu−, trp−, and ura− plate. (B) LAG1Hstransformants. B1–B4 were the same as A1–A4. (C) LAG1Hs transformants. (C1) Double (LAG1Sc and LAC1Sc) deletion haploid cells transformed with pJR1588 plasmid alone. (C2) Double deletion haploid cells transformed with pJR1588 containing LAG1Hs. Haploid double deletion cells were maintained by pRS416 containingLAG1Sc, which was replaced by the pJR1588 derivative on 5-FOA+ ura+ plates incubated for 6 days.











